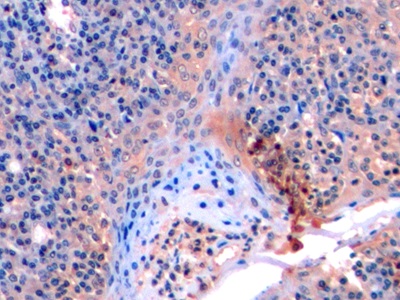

Monoclonal Antibody to Matrix Metalloproteinase 9 (MMP9)
GELB; Gelatinase B; CLG4B; CLG4-B; 92 KDa Gelatinase; 92kDa Type IV Collagenase
- Product No.MAA553Hu21
- Organism SpeciesHomo sapiens (Human) Same name, Different species.
- SourceMonoclonal antibody preparation
- HostMouse
- Potency (Clone Number)2#
- Ig Isotype IgG1 Kappa
- PurificationProtein A + Protein G affinity chromatography
- LabelNone
- Immunogen RPA553Hu01-Recombinant Matrix Metalloproteinase 9 (MMP9)
- Buffer FormulationPBS, pH7.4, containing 0.02% NaN3, 50% glycerol.
- TraitsLiquid
- Concentration1mg/mL
- Organism Species Moren/a
- ApplicationsIHC
If the antibody is used in flow cytometry, please check FCM antibodies. - DownloadInstruction Manual
- UOM 20µl100µl 200µl 1ml 10ml
- FOB
US$ 90
US$ 210
US$ 300
US$ 750
US$ 3000
For more details, please contact local distributors!
SPECIFITY
The antibody is a mouse monoclonal antibody raised against MMP9. It has been selected for its ability to recognize MMP9 in immunohistochemical staining and western blotting.
USAGE
Western blotting: 0.01-2µg/mL;
Immunohistochemistry: 5-20µg/mL;
Immunocytochemistry: 5-20µg/mL;
Optimal working dilutions must be determined by end user.
STORAGE
Store at 4°C for frequent use. Stored at -20°C in a manual defrost freezer for two year without detectable loss of activity. Avoid repeated freeze-thaw cycles.
STABILITY
The thermal stability is described by the loss rate. The loss rate was determined by accelerated thermal degradation test, that is, incubate the protein at 37°C for 48h, and no obvious degradation and precipitation were observed. The loss rate is less than 5% within the expiration date under appropriate storage condition.
GIVEAWAYS
INCREMENT SERVICES
-
 Antibody Labeling Customized Service
Antibody Labeling Customized Service
-
 Protein A/G Purification Column
Protein A/G Purification Column
-
 Staining Solution for Cells and Tissue
Staining Solution for Cells and Tissue
-
 Positive Control for Antibody
Positive Control for Antibody
-
 Tissue/Sections Customized Service
Tissue/Sections Customized Service
-
 Phosphorylated Antibody Customized Service
Phosphorylated Antibody Customized Service
-
 Western Blot (WB) Experiment Service
Western Blot (WB) Experiment Service
-
 Immunohistochemistry (IHC) Experiment Service
Immunohistochemistry (IHC) Experiment Service
-
 Immunocytochemistry (ICC) Experiment Service
Immunocytochemistry (ICC) Experiment Service
-
 Flow Cytometry (FCM) Experiment Service
Flow Cytometry (FCM) Experiment Service
-
 Immunoprecipitation (IP) Experiment Service
Immunoprecipitation (IP) Experiment Service
-
 Immunofluorescence (IF) Experiment Service
Immunofluorescence (IF) Experiment Service
-
 Buffer
Buffer
-
 DAB Chromogen Kit
DAB Chromogen Kit
-
 SABC Kit
SABC Kit
-
 Long-arm Biotin Labeling Kit
Long-arm Biotin Labeling Kit
-
 Real Time PCR Experimental Service
Real Time PCR Experimental Service
| Magazine | Citations |
| Journal of Bone and Joint Surgery | Experimental osteoarthritis induced by surgical realignment of the patella in BALB/c mice PubMed: 21119180 |
| Journal of Surgical Research | Serum Levels of Matrix Metalloproteinase-2 as a Marker of Intimal Hyperplasia ScienceDirect: S0022480409001942 |
| Journal of Proteome Research | The Biological Behaviors of Rat Dermal Fibroblasts Can Be Inhibited by High Levels of MMP9 ACS: pr2006395 |
| Zahedan Journal of Research in Medical Sciences | The Effect of Acute Sub-Maximal Endurance Exercise on Serum Angiogenic Indices in Sedentary Men Zjrms: Source |
| Experimental & Translational Stroke Medicine | Early outcome and blood-brain barrier integrity after co-administered thrombolysis and hyperbaric oxygenation in experimental stroke PubMed: 21679435 |
| PLoS One | Downregulation of CD9 in Keratinocyte Contributes to Cell Migration via Upregulation of Matrix Metalloproteinase-9 PubMed: PMC3797697 |
| PLoS ONE | A Combinatorial Relative Mass Value Evaluation of Endogenous Bioactive Proteins in Three-Dimensional Cultured Nucleus Pulposus Cells of Herniated Intervertebral Discs: Identification of Potential Target Proteins for Gene Therapeutic Approaches Plosone: Source |
| Rheumatology International | Hypothermia induced by adenosine 5′-monophosphate attenuates early stage injury in an acute gouty arthritis rat model Pubmed: 23408150 |
| Clinical and Investigative Medicine | The protective effect of dexmedetomidine on bupivacaine-induced sciatic nerve inflammation is mediated by mast cells Pubmed: 23544611 |
| Acta Histochemica | RNA interference-mediated knockdown of Notch-1 inhibits migration and invasion, down-regulates matrix metalloproteinases and suppresses NF-κB signaling pathway in trophoblast cells Pubmed: 24681113 |
| International journal of colorectal disease | Expression and inhibition of matrix metalloproteinase (MMP)-8, MMP-9 and MMP-12 in early colonic anastomotic repair Pubmed: 23619615 |
| Journal of Periodontology | Effects of Photodynamic Therapy on the Clinical and Gingival Crevicular Fluid Inflammatory Biomarkers in Chronic Periodontitis: A Split-Mouth Randomized Clinical Trial Joponline: 130464 |
| Polski Przeglad Chirurgiczny | Concentration of gelatinases and their tissue inhibitors in pancreatic inflammatory and neoplastic tumors and their influence on the early postoperative course Pubmed: 23585206 |
| Thromb Haemost. | Analysis of the expression of nine secreted matrix metalloproteinases and their endogenous inhibitors in the brain of mice subjected to ischaemic stroke Pubmed:24671655 |
| Int J Clin Exp Med. | Celastrol may have an anti-atherosclerosis effect in a rabbit experimental carotid atherosclerosis model Pubmed:Pmc4132129 |
| The Scientific World Journal | Pass-predicted hepatoprotective activity of Caesalpinia sappan in thioacetamide-induced liver fibrosis in rats Pubmed:24701154 |
| Journal of Perinatology | Increased expression of prostasin contributes to early-onset severe preeclampsia through inhibiting trophoblast invasion Pubmed:25078863 |
| World J Emerg Med | Changes in biological behaviors of rat dermal fibroblasts induced by high expression of MMP9 Pubmed:25215164 |
| PLOS ONE | Melissa officinalis Extract Inhibits Laser-Induced Choroidal Neovascularization in a Rat Model Pubmed:25314292 |
| Stem Cells International | Matrix Metalloproteinase 9 Secreted by Hypoxia Cardiac Fibroblasts Triggers Cardiac Stem Cell Migration In Vitro Pubmed:25767513 |
| Physiology and Pharmacology | A Study on the Serum Levels of Angiogenic Factors in Response to Acute Long-term Submaximal Exercise in Sedentary Men Phypha:Source |
| Mediators of Inflammation | Metalloproteinases and Their Tissue Inhibitors in Comparison between Different Chronic Pneumopathies in the Horse Journals: Mi |
| Journal of Biomaterials and Tissue Engineering | MicroRNA-506 Up-Regulation Inhibits Growth and Invasion in Non-Small Cell Lung Cancer Cells by Possibly Targeting Sphingosine Kinase 1 Content: Asp |
| PLOS | Adiponectin Attenuates Lung Fibroblasts Activation and Pulmonary Fibrosis Induced by Paraquat PubMed: 25945502 |
| Biomedical Materials | In vivo PubMed: 25634132 |
| Histol Histopathol | Estrogen-deficient osteoporosis enhances the recruitment and activity of osteoclasts by breast cancer cells PubMed: 26254457 |
| Int J Clin Exp Pathol | Up-regulation of microRNA-302a inhibited the proliferation and invasion of colorectal cancer cells by regulation of the MAPK and PI3K/Akt signaling pathways PubMed: 26191138 |
| Hattori and Ishihara Stem Cell Research & Therapy | Altered protein secretions during interactions between adipose tissue-or bone marrow-derived stromal cells and inflammatory cells PubMed: 25884474 |
| Neuropeptides | Melanocortin MC5 receptor agonists alleviate brain damage in abdominal compartment syndrome in the rat PubMed: 25616531 |
| Veterinary Parasitology | Expression of adhesion molecules, chemokines and matrix metallo- proteinases (MMPs) in viable and degenerating stage of Taenia solium metacestode in swine neurocysticercosis PubMed: 26412140 |
| Canadian Journal of Physiology and Pharmacology | Resveratrol reduces matrix metalloproteinases and alleviates intrahepatic cholestasis of pregnancy in rats Doi: Abs |
| PLASTIC AND AESTHETIC RESEARCH | A comparative study to evaluate the effect of limited access dressing on diabetic ulcers Article: 2347-9264 |
| Kyselov | Влияние диуретиков с антиальдостероновым действием на состояние межклеточного матрикса и раннее постинфарктное ремоделирование левого … Article: View |
| Оригинальные исследования / Original researches | матриксу та ранн Article: Viewfile |
| Int J Mol Sci | Evodiamine Attenuates PDGF-BB-Induced Migration of Rat Vascular Smooth Muscle Cells through Activating PPARγ PubMed: 26703570 |
| Deletion Polymorphism and Chronic Obstructive Pulmonary Disease | ReCavia (Guinea pig )lation of Viral Infection-induced Airway Remodeling Cytokine Production by the TLR3-EGFR Signaling Pathway in Human Bronchial Epithelial Cells Pubmed:27075970 |
| Basic Research | CTGF upreCavia (Guinea pig )lation correlates with MMP-9 level in airway remodeling in a murine model of asthma Journal:27699 |
| Journal of Cellular and Molecular Medicine | Chronic myelogenous leukaemia exosomes modulate bone marrow microenvironment through activation of epidermal growth factor receptor Pubmed:27196940 |
| Journal of Stroke and Cerebrovascular Diseases | Epigallocatechin Gallate Extends the Therapeutic Window of Recombinant Tissue Plasminogen Activator Treatment in Ischemic Rats Pubmed:26851971 |
| Journal of the Science of Food and Agriculture | Actein protects against methylglyoxal-induced oxidative damage in osteoblastic MC3T3-E1 cells Pubmed:26991449 |
| Cell Physiol Biochem. | MicroRNA-340 Induces Apoptosis and Inhibits Metastasis of Ovarian Cancer Cells by Inactivation of NF-x03BA;B1 Pubmed:27160777 |
| Int Wound J. | From varices to venous ulceration: the story of chronic venous disease described by metalloproteinases. Pubmed:26991748 |
| Onco Targets Ther. | sequential measurements of serum matrix metalloproteinase 9 to monitor chemotherapy responses in patients with advanced non-small-cell lung cancer pmc:PMC4898419 |
| Am J Pathol. | Serum Osteopontin as a Novel Biomarker for Muscle Regeneration in Duchenne Muscular Dystrophy. Pubmed:26963343 |
| Biochem Pharmacol. | Gallium, a promising candidate to disrupt the vicious cycle driving osteolytic metastases. pubmed:27378505 |
| disease markers | Serum HMGB1 as a Potential Biomarker for Patients with Asbestos-Related Diseases. pubmed:28348451 |
| Balkan Medical Journal | Anti-inflammatory and Anti-apoptotic Effect of Valproic Acid and Doxycycline Independent from MMP Inhibition in Early Radiation Damage pubmed:27761275 |
| SpringerPlus | The effect of long-term amiodarone administration on myocardial fibrosis and evolution of left ventricular remodeling in a porcine model of ischemic … pubmed:27652141 |
| Cerebrovascular Diseases Extra | Increased Plasma Matrix Metalloproteinase-9 Levels Contribute to Intracerebral Hemorrhage during Thrombolysis after Concomitant Stroke and Influenza Infection pubmed:27560521 |
| Microvascular Research | Pleiotropic effects of survivin in vascular endothelial cells. pubmed:27373518 |
| BMC Veterinary Research | Metalloproteinases and their inhibitors are influenced by inhalative glucocorticoid therapy incombination with environmental dust reduction in equine recurrent airway obstruction. pubmed:27938355 |
| Cellular Physiology and Biochemistry | MicroRNA-340 Induces Apoptosis and Inhibits Metastasis of Ovarian Cancer Cells by Inactivation of NF-x03BA;B1. pubmed:27160777 |
| Journal of Biomaterials and Tissue Engineering | MicroRNA-340 Targets NF-κB1 to Inhibit Cell Proliferation, Migration and Invasion in Hepatocellular Carcinoma Cell Line publication:306067745 |
| J Sci Food Agric. | Actein protects against methylglyoxal-induced oxidative damage in osteoblastic MC3T3-E1 cells. pubmed:26991449 |
| Sci Total Environ. | The effects of particulate matter on inflammation of respiratory system: Differences betweenmale and female. pubmed:28174048 |
| Journal of Biomaterials and Tissue Engineering | Zoledronic Acid Inhibits TGF-β1-Induced the Proliferation, Migration and EMT Through Smad Pathway in Human Gingival Fibroblasts art00008 |
| Human cell | Liver X receptor α (LXRα) promoted invasion and EMT of gastric cancer cells by regulation of NF-κB activity pubmed:28091828 |
| Human Cell | MicroRNA-124 upregulation inhibits proliferation and invasion of osteosarcoma cells by targeting sphingosine kinase 1 pubmed:27743351 |
| Experimental Parasitology | Adhesion molecules, chemokines and matrix metallo-proteinases response after albendazole and albendazole plus steroid therapy in swine neurocysticercosis pubmed:28821422 |
| Human Cell | MicroRNA-30a functions as tumor suppressor and inhibits the proliferation and invasion of prostate cancer cells by down-regulation of SIX1 pubmed:28573504 |
| Cellular Physiology and Biochemistry | The MiR-495/Annexin A3/P53 Axis Inhibits the Invasion and EMT of Colorectal Cancer Cells pubmed:29224019 |
| Evidence-Based Complementary and Alternative Medicine | Cardioprotection against Heart Failure by Shenfu Injection via TGF-β/Smads Signaling Pathway pubmed:28698735 |
| International Wound Journal | From varices to venous ulceration: the story of chronic venous disease described by metalloproteinases pubmed:26991748 |
| Fundamental & Clinical Pharmacology | Epigallocatechin-3-gallate ameliorates intrahepatic cholestasis of pregnancy by inhibiting matrix metalloproteinase-2 and matrix metalloproteinase-9 DOI:10.1111/fcp.12294 |
| Scientific Reports | Alantolactone induces apoptosis, promotes STAT3 glutathionylation and enhances chemosensitivity of A549 lung adenocarcinoma cells to doxorubicin via oxidative stress doi:10.1038/s41598-017-06535-y |
| Scientific Reports | Amphiregulin contained in NSCLC-exosomes induces osteoclast differentiation through the activation of EGFR pathway pubmed:28600504 |
| Archives of Medical Science | CTGF upregulation correlates with MMP-9 level in airway remodeling in a murine model of asthma. pubmed:28507585 |
| Molecular Medicine Reports | Lysyl oxidase is involved in synovial hyperplasia and angiogenesis in rats with collagen‑induced arthritis pubmed:28901438 |
| Surgical Innovation | A Time Course of Bevacizumab (Anti-VEGF) Effect on Rat Peritoneum: Relations Between Antiadhesive Action and Fibrin Regulation Enzymes. pubmed:28877644 |
| Journal of Neurochemistry | Liraglutide ameliorated peripheral neuropathy in diabetic rats: Involvement of oxidative stress, inflammation and extracellular matrix remodeling Pubmed:29572844 |
| Journal of Cellular Biochemistry | Matrix metalloproteinases‐2 (MMP‐2) and matrix metalloproteinases‐9 (MMP‐9) are differentially expressed in different regions of normal and preeclampsia … 10.1002:jcb.26849 |
| Inflammation | Extracellular Matrix Remodeling and Modulation of Inflammation and Oxidative Stress by Sulforaphane in Experimental Diabetic Peripheral Neuropathy Pubmed:29704151 |
| OncoTargets and Therapy | sirT4 acts as a tumor suppressor in gastric cancer by inhibiting cell proliferation, migration, and invasion Pubmed:30022839 |
| Biomed Research International | CD30 Is Highly Expressed in Chronic Obstructive Pulmonary Disease and Induces the Pulmonary Vascular Remodeling Pubmed:29984229 |
| Oncology Letters | miRNA‑199a‑5p suppresses proliferation and invasion by directly targeting NF‑κB1 in human ovarian cancer cells 10.3892:ol.2018.9170 |
| Taiwanese Journal of Obstetrics & Gynecology | HMGB1-RAGE signaling pathway in pPROM Pubmed:29673663 |
| Journal of Veterinary Science | Clinical assessment after human adipose stem cell transplantation into dogs Pubmed:29284215 |
| Life Sciences | Inhibition of SRC/FAK cue: A novel pathway for the synergistic effect of rosuvastatin on the anti-cancer effect of dasatinib in hepatocellular carcinoma Pubmed: 30292831 |
| Pediatric Research | Anti-thymic stromal lymphopoietin antibody suppresses airway remodeling in asthma through reduction of MMP and CTGF. Pubmed: 30464333 |
| Journal of cellular physiology | Targeting peptidylarginine deiminase reduces neutrophil extracellular trap formation and tissue injury in severe acute pancreatitis Pubmed: 30515825 |
| Clinical and experimental pharmacology & physiology | A prospective, randomized trial of intravenous hydroxocobalamin versus norepinephrine or saline for treatment of lipopolysaccharide‐induced hypotension in a swine … Pubmed: 30575111 |
| Journal of Ocular Pharmacology and Therapeutics | Evaluation of the Effects of Biohcly in an Model of Mechanical Wounds in the Rabbit Cornea Pubmed: 30888249 |
| Advanced Healthcare Materials | Impact of Hydrogel Elasticity and Adherence on Osteosarcoma Cells and Osteoblasts Pubmed: 30838809 |
| Cellular & Molecular Biology Letters | MiR-613 inhibits proliferation and invasion and induces apoptosis of rheumatoid arthritis synovial fibroblasts by direct down-regulation of DKK1 |
| ARCHIVES OF ORAL BIOLOGY | Histopathological and Biochemical Evaluation of the effect of Paeoniflorin on the Periodontium During and After Periodontitis Formation in Rats Pubmed: 31005686 |
| МАТРИКСНЫЕ МЕТАЛЛОПРОТЕИНАЗЫ: ЗНАЧЕНИЕ В РЕМОДЕЛИРОВАНИИ СЕРДЦА У ПАЦИЕНТОВ С ДИСПЛАЗИЕЙ СОЕДИНИТЕЛЬНОЙ ТКАНИ | |
| Mediators of Inflammation | Metalloproteinases and their Inhibitors under the Course of Immunostimulation by CPG-ODN and Specific Antigen Inhalation in Equine Asthma |
| International Journal of Clinical and Experimental Medicine | Expression of MMP-9 and TIMP-1 in rat models of pressure ulcer and their significance |
| Antioxidants | Hydroxytyrosol Supplementation Modifies Plasma Levels of Tissue Inhibitor of Metallopeptidase 1 in Women with Breast Cancer Pubmed: 31514476 |
| Journal of Obstetrics and Gynaecology Research | The levels of matrix metalloproteinase-9 and neutrophil gelatinase-associated lipocalin in different stages of endometriosis Pubmed: 31177884 |
| Archives of Insect Biochemistry and Physiology | Evaluation of the anti-atherogenic potential of Egyptian artichoke leaf extract in hypercholesterolemic rats Pubmed: 31566004 |
| Medicina | Proportion of the CD19-Positive and CD19-Negative Lymphocytes and Monocytes within the Peripheral Blood Mononuclear Cell Set Is Characteristic for Rheumatoid … Pubmed: 31554310 |
| Oncology Research | MicroRNA-6884-5p regulates the proliferation, invasion and EMT of gastric cancer cells by directly targeting S100A16 Pubmed: 31796150 |
| Open Medicine | Plasma matrix metalloproteinase-9 and tissue inhibitor of matrix metalloproteinase-1 as prognostic biomarkers in critically ill patients Pubmed: 32190734 |
| Scientific Reports | Matrix metallopeptidase expression and modulation by transforming growth factor-β1 in equine endometrosis Pubmed: 31980722 |
| JOURNAL OF THROMBOSIS AND THROMBOLYSIS | Extracellular matrix collagen biomarkers levels in patients with chronic thromboembolic pulmonary hypertension Pubmed: 33175289 |
| Eur J Pharmacol | TLR3 inhibitor and tyrosine kinase inhibitor attenuate cigarette smoke/poly I: C-induced airway inflammation and remodeling by the EGFR/TLR3/MAPK … Pubmed: 33068589 |
| Cancers | Multiple Myeloma-Derived Extracellular Vesicles Induce Osteoclastogenesis through the Activation of the XBP1/IRE1α Axis Pubmed: 32759820 |
| Lab Invest | Extracellular cold-inducible RNA-binding protein regulates neutrophil extracellular trap formation and tissue damage in acute pancreatitis Pubmed: 32709888 |
| International Journal of Environmental Research and Public Health | Biomarkers Facilitate the Assessment of Prognosis in Critically Ill Patients with Primary Brain Injury: A Cohort Study Pubmed: 32575870 |
| J Cell Physiol | A novel role of VEPH1 in regulating AoSMC phenotypic switching Pubmed: 32342520 |
| JAMA Surgery | Intraoperative dexmedetomidine for prevention of postoperative delirium in elderly patients with mild cognitive impairment Pubmed: 28593326 |
| OMICS-A JOURNAL OF INTEGRATIVE BIOLOGY | Intracranial Aneurysm Biomarker Candidates Identified by a Proteome-Wide Study Pubmed: 32525733 |
| Advances in Animal and Veterinary Sciences | Clinicopathological studies and new markers for trypanosoma evansi in experimen-tally infected rats |
| International Journal of Pharmacology | Anti-arthritic Effects of Platelets Rich Plasma and Hyaluronic Acid on Adjuvant-induced Arthritis in Rats |
| Asian Journal of Pharmacy and Pharmacology | Evaluation of altered ground matrix and matrix metalloproeinase (MMP'S) in wound healing with Aloe vera extract |
| Veterinary Sciences: Research and Reviews | Investigation of matrix metalloproteinase-2 and matrix metalloproteinase-9 activity in some inflammatory conditions in Barki sheep |
| Identification of Polyphenolic Compounds and Hepatoprotective Activity of Artichoke (Cynara Scolymus L.) Edible Part Extracts in Rats | |
| Клиническая медицина | ДИНАМИКА МАРКЕРА ФИБРОЗИРОВАНИЯ ММР-9 У БОЛЬНЫХ ЛИМФОМОЙ ХОДЖКИНА |
| ENVIRONMENTAL SCIENCE AND POLLUTION RESEARCH | Krill oil and low-dose aspirin combination mitigates experimentally induced silicosis in rats: role of NF-¦ÊB/TGF-¦Â1/MMP-9 pathway 33398741 |
| Oncol Lett | GATA3 is downregulated in HCC and accelerates HCC aggressiveness by transcriptionally inhibiting slug expression 33613720 |
| CLINICAL SCIENCE | Berberine accelerated wound healing by restoring TrxR1/JNK in diabetes 33491733 |
| Sci Rep | Association between MIF gene promoter rs755622 and susceptibility to coronary artery disease and inflammatory cytokines in the Chinese Han population 33850223 |
| MOLECULAR VISION | Quantification of a panel for dry-eye protein biomarkers in tears: A comparative pilot study using standard ELISA and customized microarrays 34012227 |
| Journal of Pregnancy | Matrix Metalloproteinases MMP-2 and MMP-9 Occupy a New Role in Severe Preeclampsia 33381317 |
| Stem Cells International | The Paracrine Effect of Adipose-Derived Stem Cells Orchestrates Competition between Different Damaged Dermal Fibroblasts to Repair UVB-Induced Skin?¡ 33381190 |
| DOCSBAY | Intermittent Pacing Therapy Favorably Modulates Infarct Remodeling 28386775 |
| Drug Chem Toxicol | Study of cardioprotective activity of the methanolic extract of the aerial parts of Bauhinia madagascariensis compared to Bauhinia purpurea against adrenaline … 34167392 |
| JOURNAL OF FLUORESCENCE | Time-resolved Fluorescence Immunoassay (TRFIA) for the Simultaneous Detection of MMP-9 and Lp-PLA2 in Serum 34495467 |
| CNS Neurosci Ther | Alterations in the gut microbiome with hemorrhagic transformation in experimental stroke 34591349 |
| Calcium Binding Protein S100A16 Expedites Proliferation, Invasion and EMT Process in Gastric Cancer 34650982 | |
| Disease Markers | Urinary Matrix Metalloproteinase-9 and Nephrin in Idiopathic Membranous Nephropathy: A Cross-Sectional Study 34707724 |
| Medicina (Kaunas) | Plasma Concentrations of New Biochemical Markers of Atherosclerosis in Patients with Dyslipidemia—A Pilot Study Pubmed:35743980 |
| Biomolecules | Increase in Serum MMP-9 and TIMP-1 Concentrations during Alcohol Intoxication in Adolescents—A Preliminary Study Pubmed:35625637 |
| Journal of Pharmaceutical Research International | Concomitant Administration of Rosuvastatin and Lefleunamide in Low doses Synergize Against Complete Freund's Adjuvant (CFA)-Induced Rheumatoid … |
| Non-POU Domain-Containing Octamer-Binding (NONO) Protein Stability Regulated by PIN1 is Crucial for Breast Cancer Tumorigenicity Via the MAPK/β … | |
| Turkish Journal of Biochemistry-Turk Biyokimya Dergisi | Downregulation of MMP-2 and MMP-9 genes in obesity patients and their relation with obesity-related phenotypes |